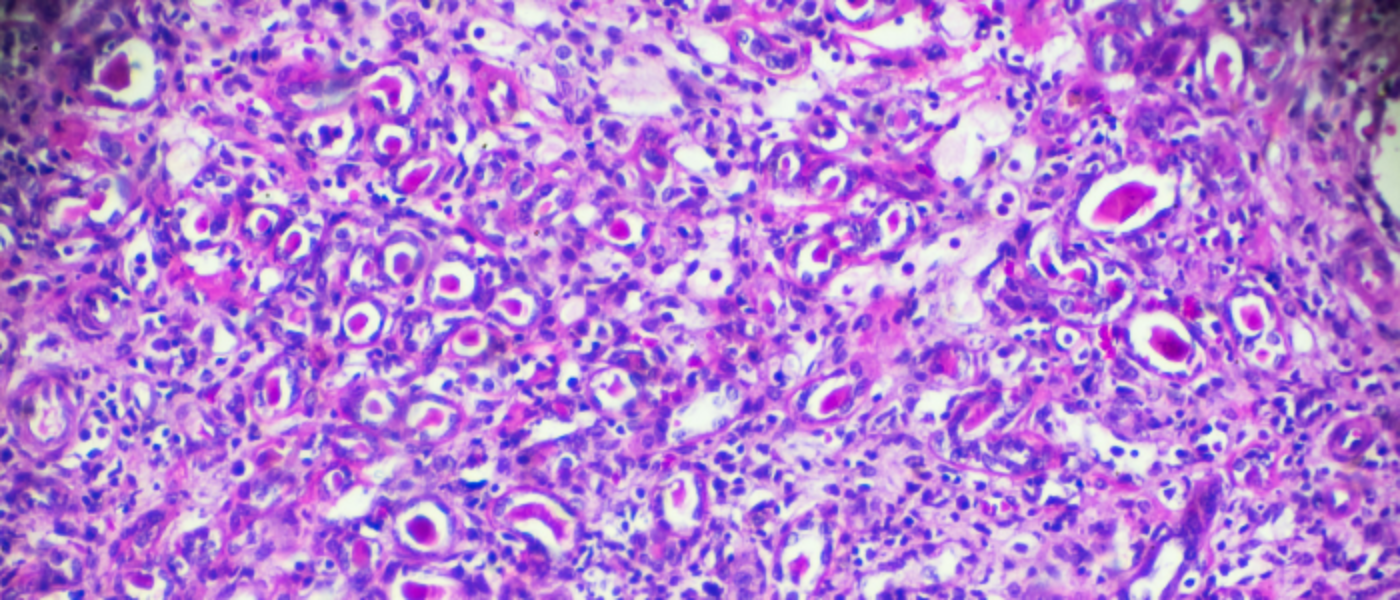

Glomerulonephritis in Runwal Nagar is a serious kidney condition where the tiny filters of the kidneys, called glomeruli, become inflamed. At Hope Kidney Care, accurate diagnosis and timely treatment help prevent long-term damage.
The condition may be caused by infections, autoimmune diseases, or genetic factors. Symptoms include blood in urine, swelling, and high blood pressure. If left untreated, it can lead to chronic kidney disease.
The nephrologists at Hope Kidney Care use blood tests, urine analysis, and kidney biopsy to confirm the diagnosis. Treatment depends on the cause but may involve medications to control inflammation, blood pressure, or immune response. In severe cases, dialysis or transplant evaluation may be needed.
If you are searching for expert care for glomerulonephritis in Runwal Nagar, Hope Kidney Care provides specialized treatment with a patient-centered approach. Contact us today to book your consultation.








